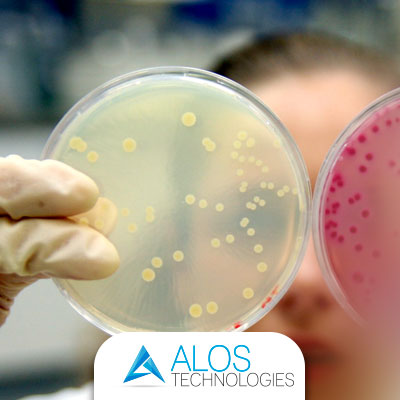
Come si trasmettono le infezioni batteriche in ospedale

Alos Technologies - ultime notizie
La sezione riporta le novità nei servizi e nelle attività di progettazione, di produzione e di commercializzazione dei dispositivi medici; di apparecchiature per i monitoraggi dei Gas e dell'ambiente. Un canale sempre puntato sulle più recenti scoperte dei sistemi nel settore della sanità, per una migliore informazione e conoscenza di tutti.

- Dettagli
- Scritto da Creare
Sicurezza, affidabilità e certezza del lavoro, seguito passo passo da un team di esperti che offre professionalità e qualità.
Alos Technologies si affida, infatti, ai migliori esperti del settore per la fornitura di pareti attrezzate e tavoli operatori, garantendo così elevati standard di sicurezza richiesti dalle strutture cliniche e ospedaliere. Una volta finito il lavoro Alos Technologies offre una costante assistenza e presenza sia negli uffici, sia sul territorio.

- Dettagli
- Scritto da Creare
La qualità dell’aria e della salute è alla base del “vivere quotidiano” delle persone.
Avere un ambiente salubre per tutti coloro che transitano e vivono in uno stesso habitat non è solo una pratica corretta, ma un dovere morale e legale, soprattutto se consideriamo quelle aree più esposte o a rischio contaminazione, come gli ambienti medici od ospedalieri.
- Dettagli
- Scritto da Creare
Negli ospedali, vista la presenza di molti pazienti può succedere di contrarre infezioni batteriche.
Le infezioni ospedaliere, o “nosocomiali”, sono particolarmente pericolose perché possono radicarsi con facilità in soggetti sensibili.
D'altronde la presenza di malati crea un terreno molto fertile per i microorganismi; di conseguenza la trasmissione delle infezioni dalla fonte all’ospite potrebbe essere più veloce di quanto si pensi.
Ma come si trasmettono le infezioni batteriche?

- Dettagli
- Scritto da Creare
Negli ospedali, soprattutto nei reparti operatori, l’igiene è fondamentale.
Il reparto operatorio nelle strutture ospedaliere è quello che per la maggior parte necessita di pulizia e costante manutenzione.
Non si tratta infatti soltanto di garantire la temperatura ottimale per gli interventi e le attività previste ma la sala operatoria dev’essere igienizzata e pulita attraverso interventi ordinari.

- Dettagli
- Scritto da Creare
Ogni scoperta scientifica realizzata nel corso della storia dell’umanità ha due elementi in comune: i pericoli e le potenzialità, che sono sempre stati sperimentati sul campo da soggetti spesso ignari di ciò che stava succedendo.
Un esempio di effetti pericolosi sul campo sono quelli derivati proprio dai gas anestetici.

- Dettagli
- Scritto da Creare
Negli ambienti, soprattutto in quelli sovraffollati come gli ospedali, scuole, teatri, uffici, negozi e centri commerciali è importante verificare costantemente la qualità dell’aria negli impianti.
Tenere pulite le condotte d’aria, oltre che un obbligo di legge, è un impegno per la salute collettiva che può migliorare la qualità della vita.
